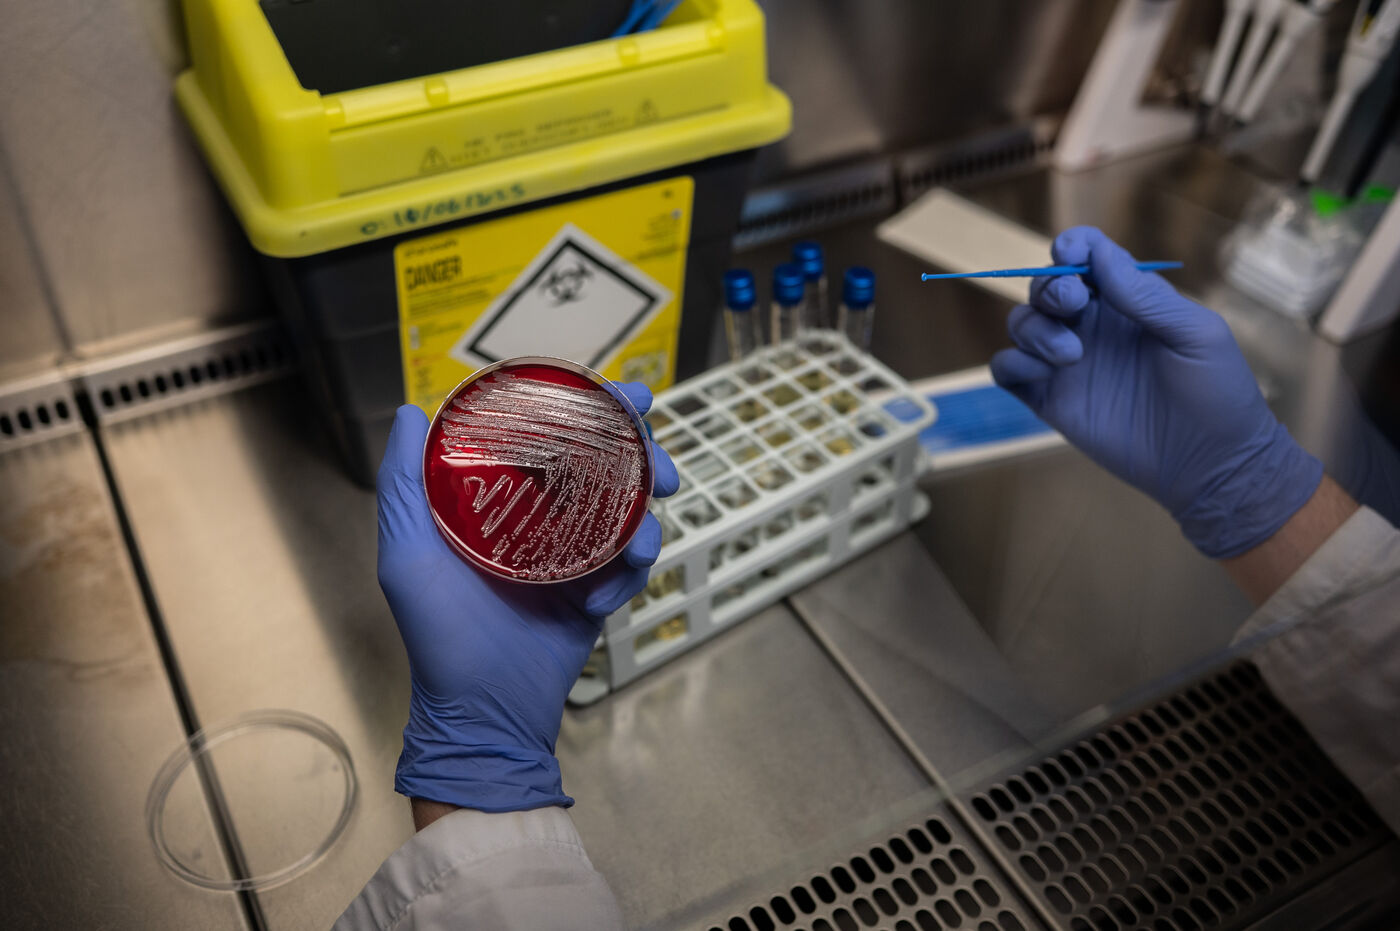

Pour accéder à la série en entier, vous devez vous logger ou demander un compte Hans Lucas en cliquant ici.
Unité de recherche de bactériophages
Etudes des bactériophages au sein de l'Institut des agents infectieux à l'hôpital de la Croix-Rousse.
France, Lyon, 2025-06-24.
Unité de recherche de bactériophages
Study of bacteriophages at the Institute of Infectious Agents at Croix-Rousse Hospital.
France, Lyon, June 24, 2025.